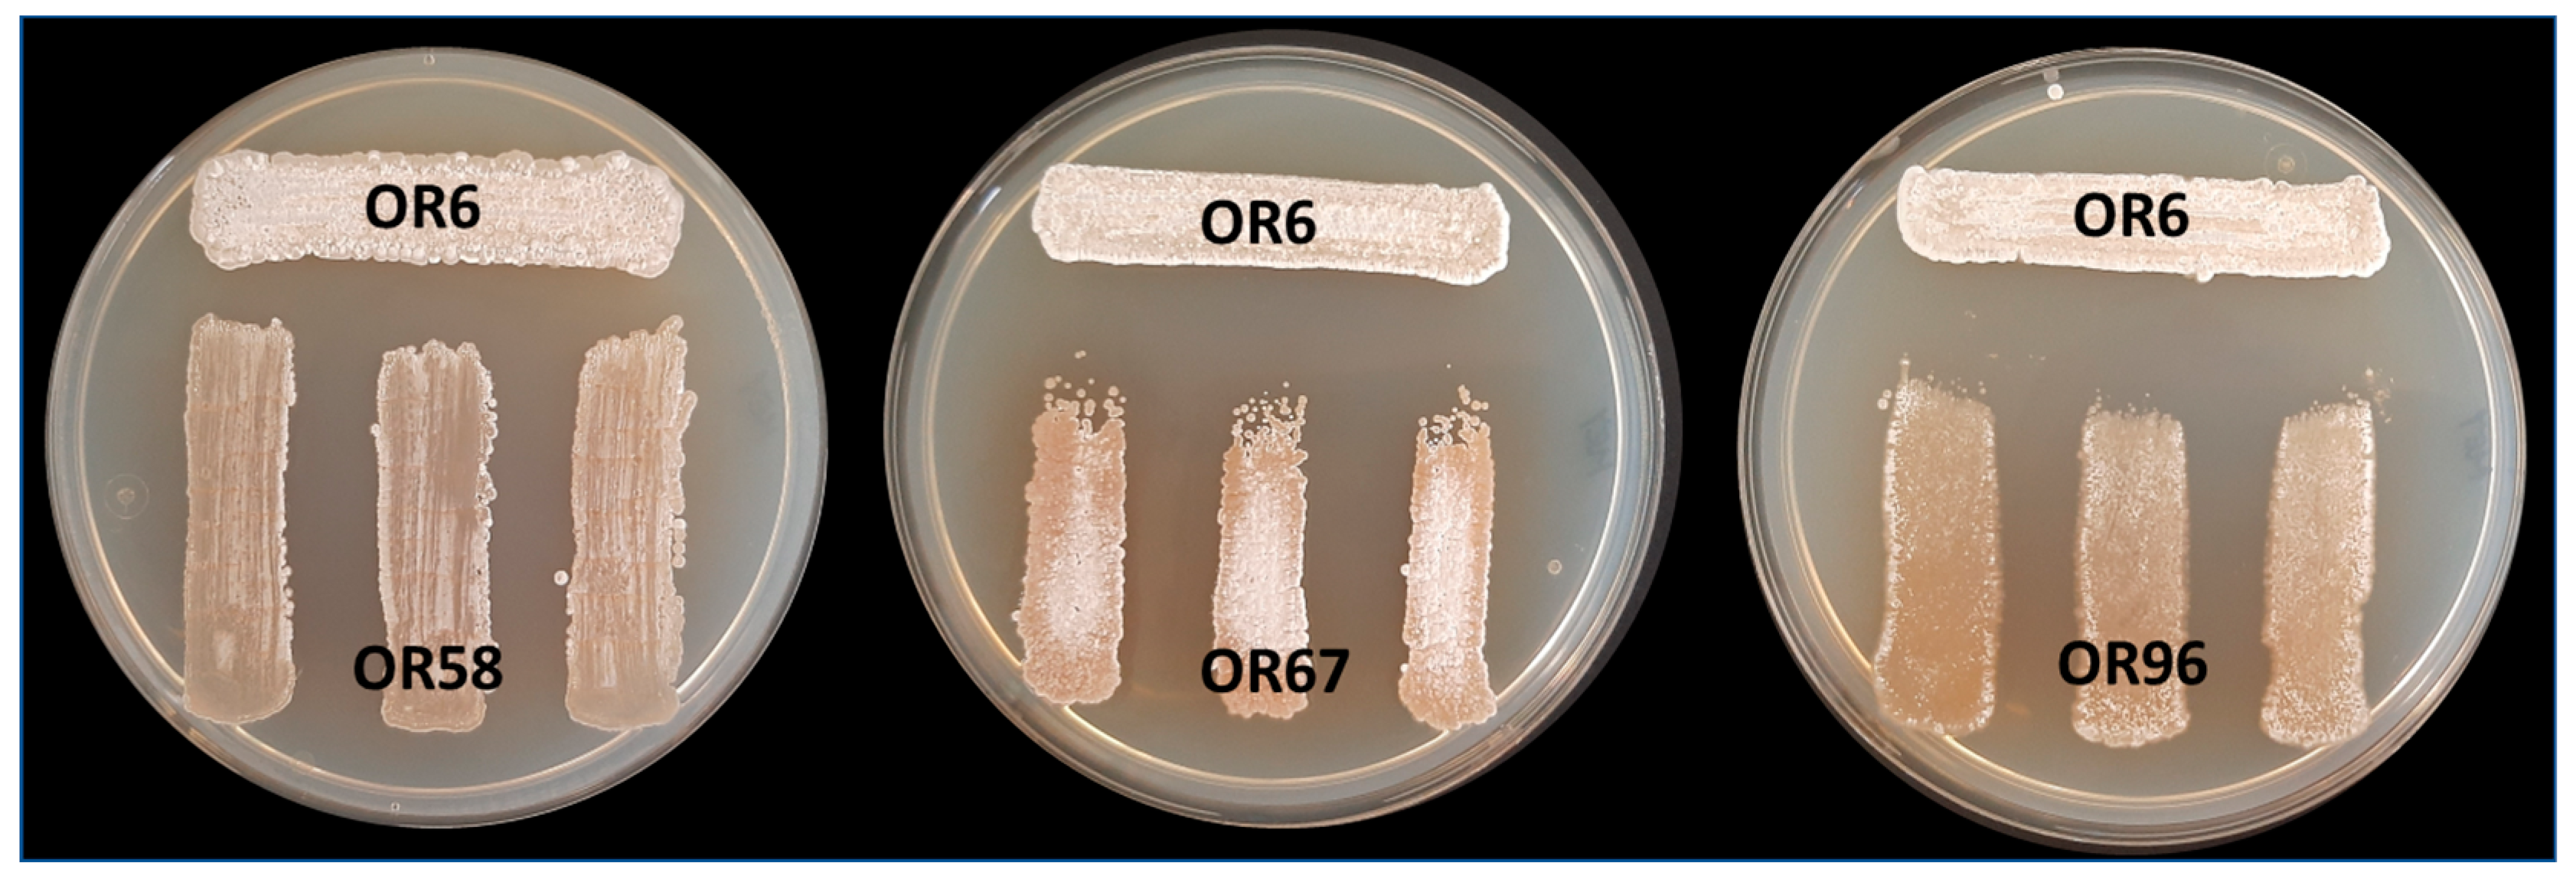
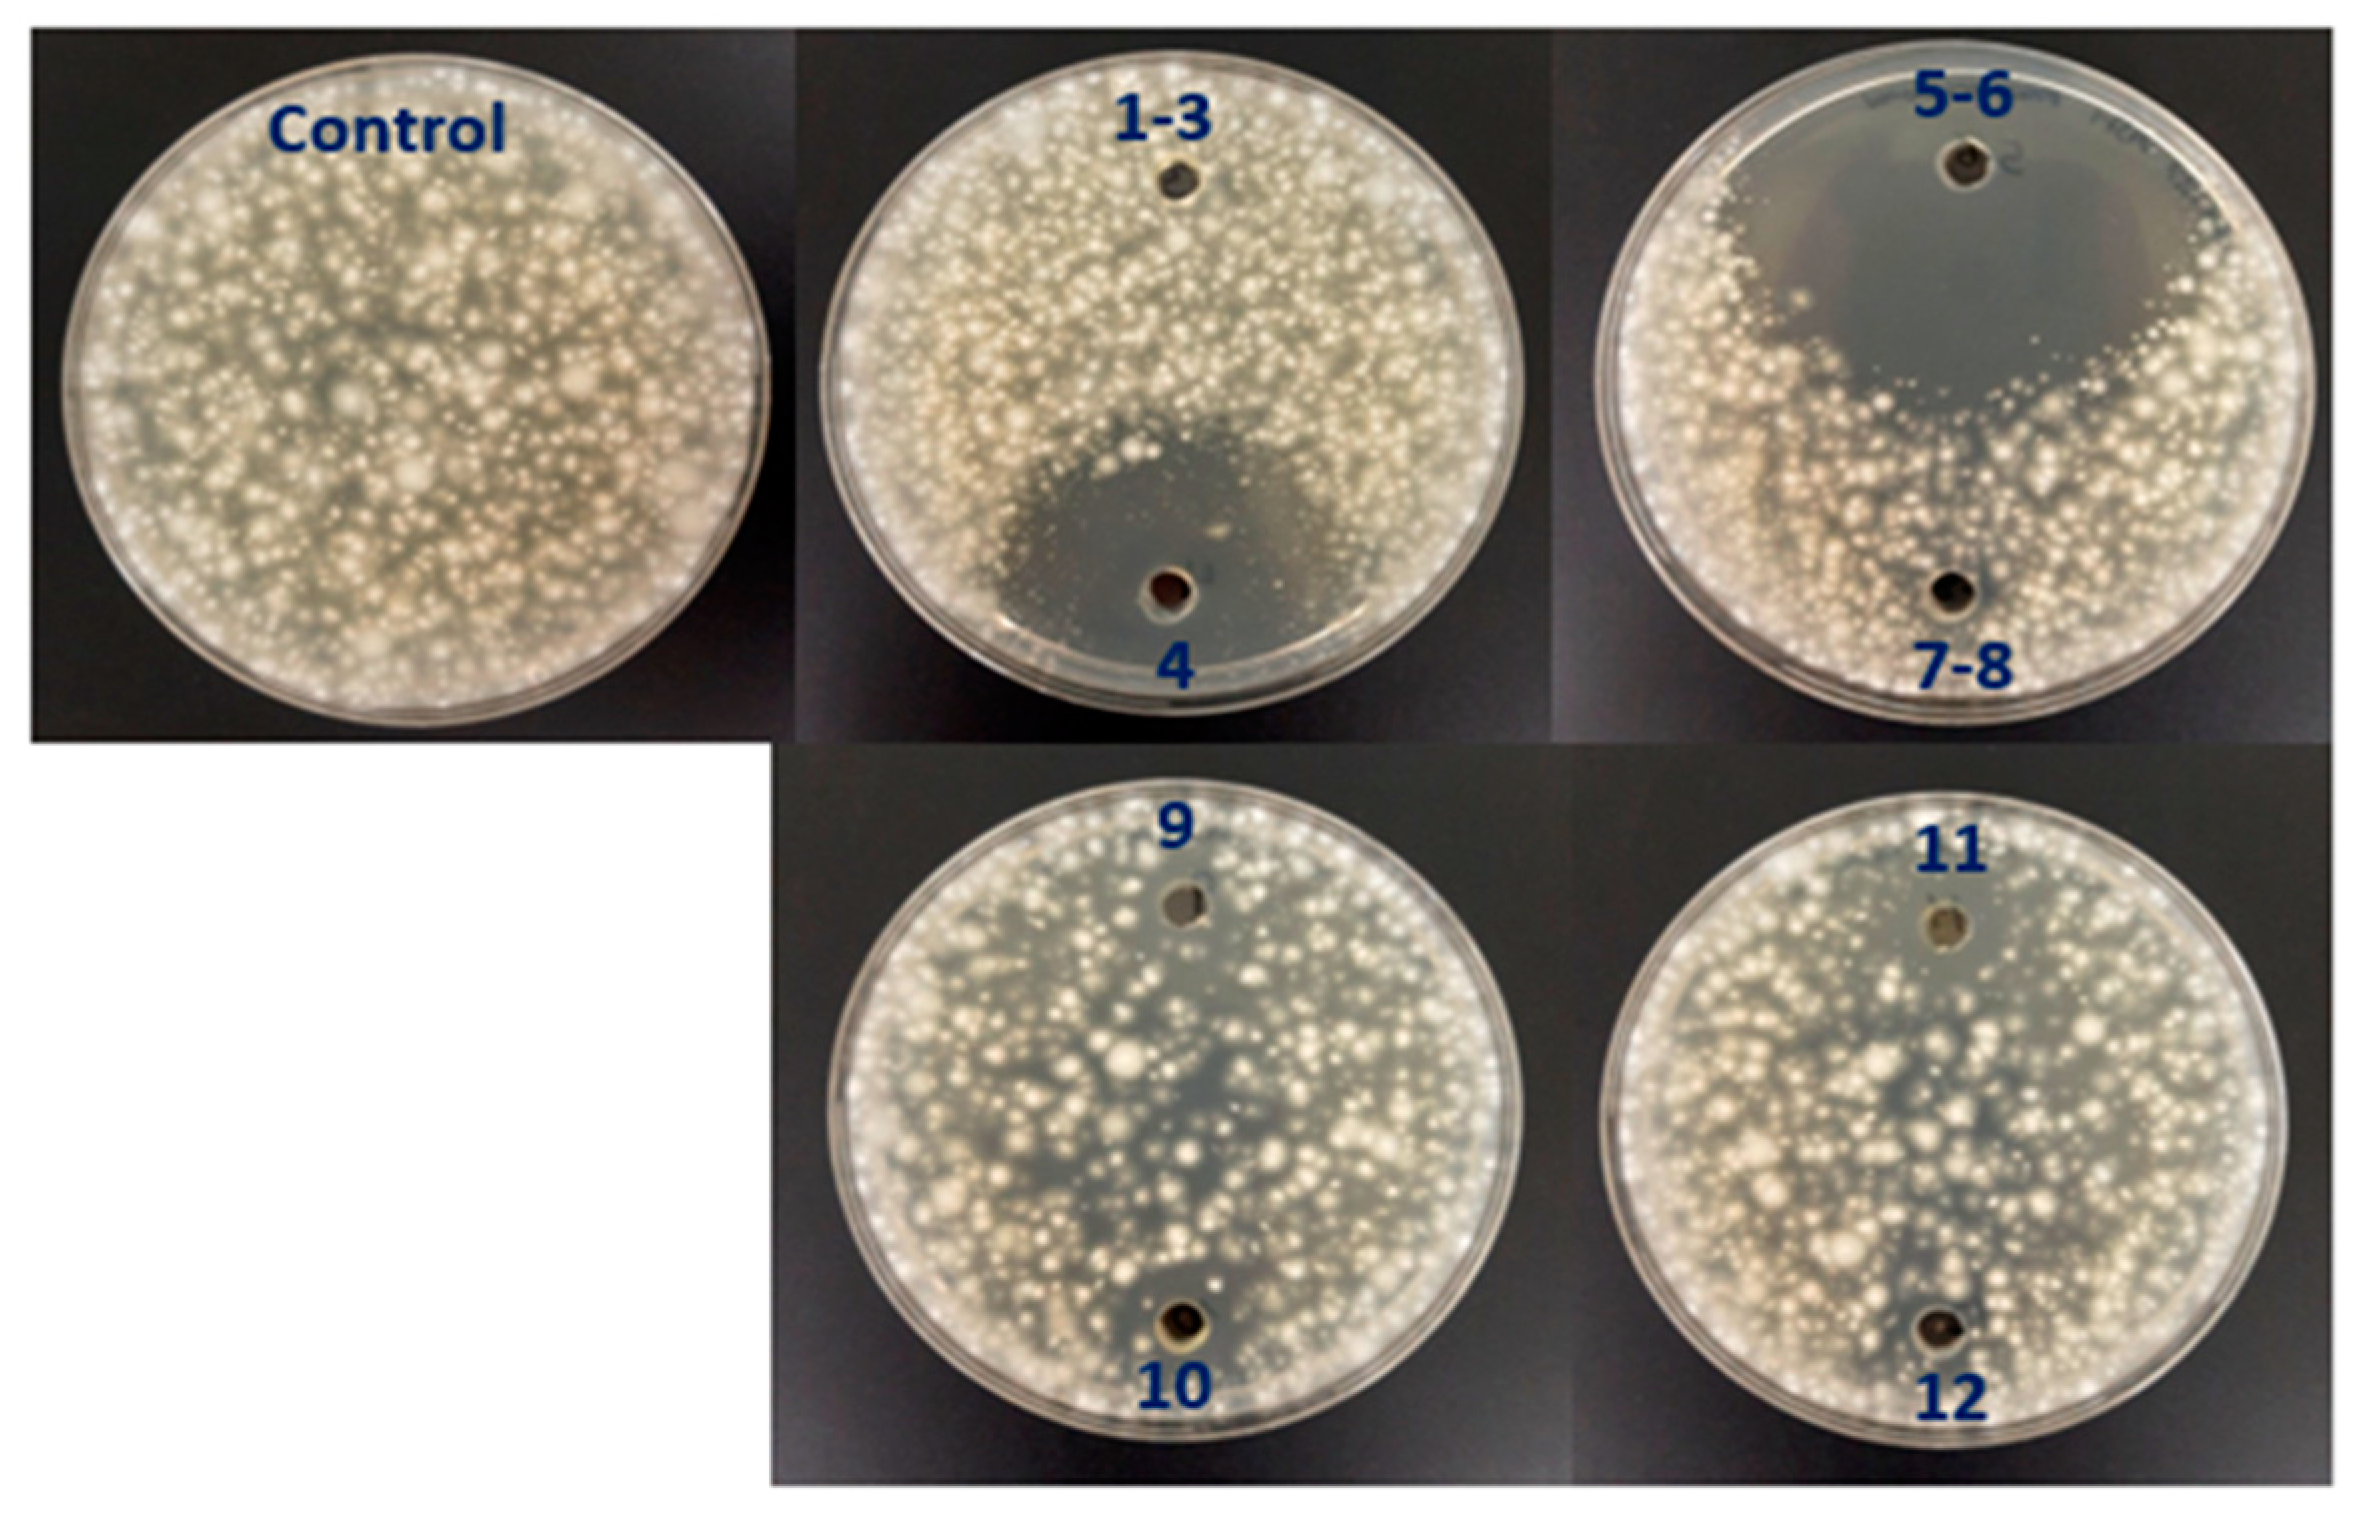

Albocycline Is the Main Bioactive Antifungal Compound Produced by Streptomyces sp. OR6 against Verticillium dahliae
Abstract
1. Introduction
2. Results
2.1. Isolation and Selection of Culturable Streptomycetes Associated with the Olive Rhizosphere and Their Antifungal Activity
2.2. Molecular Identification of the Selected Isolates by Partial Sequencing of 16S rRNA and Multilocus Sequence Analysis (MLSA)
2.3. Strain-Specific Patterns of Inhibition in Streptomyces–Streptomyces Interaction Bioassays
2.4. Analysis of AF Activity Due to Volatile Organic Compounds (VOCs)
2.5. Analysis of the Antifungal Activity of the Selected Strains in Small-Scale Soil Tests
2.6. Identification of Albocycline as the Main Antifungal Compound Produced by OR6
2.7. Effect of Albocycline on the Germination of V. dahliae Conidiospores and Sclerotia and Calculation of MIC Value
3. Discussion
4. Materials and Methods
4.1. Isolation of Culturable Streptomycetes Strains from the Rhizosphere of Olive Trees
4.2. Preliminary Identification of Strains by 16S rRNA Sequencing
4.3. Identification by Multilocus Sequence Analysis (MLSA)
4.4. In Vitro Selection of Isolates by Their AF Activity in Plate Assays
4.5. Analysis of Antifungal Activity of Volatile Organic Compounds (VOCs)
4.6. Analysis of AF Activity in Liquid Culture Media and in Fractions Obtained during Albocycline Purification Process
4.7. Confrontation of Rhizosphere Streptomyces sp. Isolates with Each Other
4.8. Analysis of AF Activity in Small-Scale Soil Tests
4.9. Soil Physicochemical Properties
4.10. Obtaining Crude Extracts and HPLC Analysis
4.11. Purification of Albocycline by Vacuum Flash Chromatography (VFC)
4.12. Structural Elucidation of Albocycline
4.13. Analysis of the Ability of Albocycline to Inhibit Conidiospore Germination
5. Conclusions
Supplementary Materials
Author Contributions
Funding
Data Availability Statement
Acknowledgments
Conflicts of Interest
References
- Inderbitzin, P.; Subbarao, K.V. Verticillium Systematics and Evolution: How Confusion Impedes Verticillium Wilt Management and How to Resolve It. Phytopathology 2014, 104, 564–574. [Google Scholar] [CrossRef]
- Klosterman, S.J.; Atallah, Z.K.; Vallad, G.E.; Subbarao, K.V. Diversity, Pathogenicity, and Management of Verticillium Species. Annu. Rev. Phytopathol. 2009, 47, 39–62. [Google Scholar] [CrossRef] [PubMed]
- Keykhasaber, M.; Thomma, B.P.H.J.; Hiemstra, J.A. Verticillium Wilt Caused by Verticillium dahliae in Woody Plants with Emphasis on Olive and Shade Trees. Eur. J. Plant Pathol. 2018, 150, 21–37. [Google Scholar] [CrossRef]
- Gent, D.H.; Woods, J.L.; Putnam, M.L. New Outbreaks of Verticillium Wilt on Hop in Oregon Caused by Nonlethal Verticillium albo-atrum. Plant Manag. Netw. 2012, 13, 14. [Google Scholar] [CrossRef]
- López-Escudero, F.J.; Mercado-Blanco, J. Verticillium Wilt of Olive: A Case Study to Implement an Integrated Strategy to Control a Soil-Borne Pathogen. Plant Soil 2011, 344, 1–50. [Google Scholar] [CrossRef]
- Castro, D.; Torres, M.; Sampedro, I.; Martínez-Checa, F.; Torres, B.; Béjar, V. Biological Control of Verticillium Wilt on Olive Trees by the Salt-Tolerant Strain Bacillus velezensis XT1. Microorganisms 2020, 8, 1080. [Google Scholar] [CrossRef]
- Food and Agriculture Organization of the United Nations (FAO). FAOSTAT Database, Crops Processed, Data for Olive Oil; FAO: Rome, Italy, 2014. [Google Scholar]
- Ministerio de Agricultura. Alimentación y Medio Ambiente (MAGRAMA). Avances de Superficies y Producciones de Cultivos. Available online: https://www.mapa.gob.es/es/estadistica/temas/estadisticas-agrarias/agricultura/avances-superficies-producciones-agricolas/2012-2015.aspx (accessed on 10 July 2020).
- López-Escudero, F.J.; Mercado-Blanco, J.; Roca, J.M.; Valverde-Corredor, A.; Blanco-López, M.A. Verticillium Wilt of Olive in the Guadalquivir Valley (Southern Spain): Relations with Some Agronomical Factors and Spread of Verticillium dahliae. Phytopathol. Mediterr. 2010, 49, 370–380. [Google Scholar] [CrossRef]
- Montes-Osuna, N.; Mercado-Blanco, J. Verticillium Wilt of Olive and Its Control: What Did We Learn during the Last Decade? Plants 2020, 9, 735. [Google Scholar] [CrossRef]
- Coque, J.J.R.; Álvarez-Pérez, J.M.; Cobos, R.; González-García, S.; Ibáñez, A.M.; Diez Galán, A.; Calvo-Peña, C. Advances in the Control of Phytopathogenic Fungi That Infect Crops through Their Root System. In Advances in Applied Microbiology; Gadd, G.M., Sariaslani, S., Eds.; Academic Press Inc.: Cambridge, MA, USA, 2020; Volume 111, pp. 123–170. [Google Scholar]
- Mulero-Aparicio, A.; Agustí-Brisach, C.; Varo, Á.; López-Escudero, F.J.; Trapero, A. A Non-Pathogenic Strain of Fusarium oxysporum as a Potential Biocontrol Agent against Verticillium Wilt of Olive. Biol. Control 2019, 139, 104045. [Google Scholar] [CrossRef]
- Mulero-Aparicio, A.; Cernava, T.; Turrà, D.; Schaefer, A.; di Pietro, A.; López-Escudero, F.J.; Trapero, A.; Berg, G. The Role of Volatile Organic Compounds and Rhizosphere Competence in Mode of Action of the Non-Pathogenic Fusarium oxysporum FO12 toward Verticillium Wilt. Front. Microbiol. 2019, 10, 1808. [Google Scholar] [CrossRef]
- Carrero-Carrón, I.; Trapero-Casas, J.L.; Olivares-García, C.; Monte, E.; Hermosa, R.; Jiménez-Díaz, R.M. Trichoderma asperellum Is Effective for Biocontrol of Verticillium Wilt in Olive Caused by the Defoliating Pathotype of Verticillium dahliae. Crop Prot. 2016, 88, 45–52. [Google Scholar] [CrossRef]
- Varo, A.; Raya-Ortega, M.C.; Trapero, A. Selection and Evaluation of Micro-Organisms for Biocontrol of Verticillium dahliae in Olive. J. Appl. Microbiol. 2016, 121, 767–777. [Google Scholar] [CrossRef] [PubMed]
- Lozano-Tovar, M.D.; Garrido-Jurado, I.; Quesada-Moraga, E.; Raya-Ortega, M.C.; Trapero-Casas, A. Metarhizium brunneum and Beauveria Bassiana Release Secondary Metabolites with Antagonistic Activity against Verticillium dahliae and Phytophthora megasperma Olive Pathogens. Crop Prot. 2017, 100, 186–195. [Google Scholar] [CrossRef]
- Boutaj, H.; Meddich, A.; Wahbi, S.; Moukhli, A.; Alaoui-Talibi, Z.; Douira, A.; Filali-Maltouf, A.; Modafar, C. Effect of Arbuscular Mycorrhizal Fungi on Verticillium Wilt Development of Olive Trees Caused by Verticillium dahliae. Res. J. Biotechnol. 2019, 14, 79–88. [Google Scholar]
- Boutaj, H.; Chakhchar, A.; Meddich, A.; Wahbi, S.; El Alaoui-Talibi, Z.; Douira, A.; Filali-Maltouf, A.; El Modafar, C. Bioprotection of Olive Tree from Verticillium Wilt by Autochthonous Endomycorrhizal Fungi. J. Plant Dis. Prot. 2020, 127, 349–357. [Google Scholar] [CrossRef]
- Gómez-Lama Cabanás, C.; Sesmero, R.; Valverde-Corredor, A.; López-Escudero, F.J.; Mercado-Blanco, J. A Split-Root System to Assess Biocontrol Effectiveness and Defense-Related Genetic Responses in Above-Ground Tissues during the Tripartite Interaction Verticillium dahliae-Olive-Pseudomonas Fluorescens PICF7 in Roots. Plant Soil 2017, 417, 433–452. [Google Scholar] [CrossRef]
- Gómez-Lama Cabanás, C.; Legarda, G.; Ruano-Rosa, D.; Pizarro-Tobías, P.; Valverde-Corredor, A.; Niqui, J.L.; Triviño, J.C.; Roca, A.; Mercado-Blanco, J. Indigenous pseudomonas spp. Strains from the Olive (Olea europaea L.) Rhizosphere as Effective Biocontrol Agents against Verticillium dahliae: From the Host Roots to the Bacterial Genomes. Front. Microbiol. 2018, 9, 277. [Google Scholar] [CrossRef]
- Markakis, E.A.; Tjamos, S.E.; Antoniou, P.P.; Paplomatas, E.J.; Tjamos, E.C. Biological Control of Verticillium Wilt of Olive by Paenibacillus alvei, Strain K165. BioControl 2016, 61, 293–303. [Google Scholar] [CrossRef]
- Cheffi Azabou, M.; Gharbi, Y.; Medhioub, I.; Ennouri, K.; Barham, H.; Tounsi, S.; Triki, M.A. The Endophytic Strain Bacillus velezensis OEE1: An Efficient Biocontrol Agent against Verticillium Wilt of Olive and a Potential Plant Growth Promoting Bacteria. Biol. Control 2020, 142, 104168. [Google Scholar] [CrossRef]
- Bubici, G. Streptomyces spp. as Biocontrol Agents against Fusarium Species. CAB Rev. Perspect. Agric. Vet. Sci. Nutr. Nat. Resour. 2018, 13, 1–15. [Google Scholar] [CrossRef]
- Labeda, D.P.; Goodfellow, M.; Brown, R.; Ward, A.C.; Lanoot, B.; Vanncanneyt, M.; Swings, J.; Kim, S.B.; Liu, Z.; Chun, J.; et al. Phylogenetic Study of the Species within the Family Streptomycetaceae. Antonie Van Leeuwenhoek 2012, 101, 73–104. [Google Scholar] [CrossRef] [PubMed]
- Van der Meij, A.; Worsley, S.F.; Hutchings, M.I.; Van Wezel, G.P. Chemical Ecology of Antibiotic Production by Actinomycetes. FEMS Microbiol. Rev. 2017, 41, 392–416. [Google Scholar] [CrossRef] [PubMed]
- Vurukonda, S.S.K.P.; Giovanardi, D.; Stefani, E. Plant Growth Promoting and Biocontrol Activity of Streptomyces spp. as Endophytes. Int. J. Mol. Sci. 2018, 19, 952. [Google Scholar] [CrossRef] [PubMed]
- Janssen, P.H. Identifying the Dominant Soil Bacterial Taxa in Libraries of 16S RRNA and 16S RRNA Genes. Appl. Environ. Microbiol. 2006, 72, 1719–1728. [Google Scholar] [CrossRef]
- Deketelaere, S.; Tyvaert, L.; França, S.C.; Höfte, M. Desirable Traits of a Good Biocontrol Agent against Verticillium Wilt. Front. Microbiol. 2017, 8, 1186. [Google Scholar] [CrossRef]
- Rong, X.; Huang, Y. Taxonomic Evaluation of the Streptomyces Hygroscopicus Clade Using Multilocus Sequence Analysis and DNA-DNA Hybridization, Validating the MLSA Scheme for Systematics of the Whole Genus. Syst. Appl. Microbiol. 2012, 35, 7–18. [Google Scholar] [CrossRef]
- Shirling, E.B.; Gottlieb, D. Methods for the Characterization of Streptomyces Species. Int. J. Syst. Bacteriol. 1966, 16, 313–340. [Google Scholar] [CrossRef]
- Reusser, F. Mode of Action of Albocycline, an Inhibitor of Nicotinate Biosynthesis. J. Bacteriol. 1969, 100, 11–13. [Google Scholar] [CrossRef]
- Liang, H.; Zhou, G.; Ge, Y.; D’Ambrosio, E.A.; Eidem, T.M.; Blanchard, C.; Shehatou, C.; Chatare, V.K.; Dunman, P.M.; Valentine, A.M.; et al. Elucidating the Inhibition of Peptidoglycan Biosynthesis in Staphylococcus aureus by Albocycline, a Macrolactone Isolated from Streptomyces maizeus. Bioorg. Med. Chem. 2018, 26, 3453–3460. [Google Scholar] [CrossRef]
- Christner, C.; Kullertz, G.; Fischer, G.; Zerlin, M.; Grabley, S.; Thiericke, R.; Taddei, A.; Zeeck, A. Albocycline- and Carbomycin-Type Macrolides, Inhibitors of Human Prolyl Endopeptidases. J. Antibiot. 1998, 51, 368–371. [Google Scholar] [CrossRef][Green Version]
- Zucchi, T.D.; Almeida, L.G.; Dossi, F.C.A.; Cônsoli, F.L. Secondary Metabolites Produced by Propionicimonas sp. (ENT-18) Induce Histological Abnormalities in the Sclerotia of Sclerotinia Sclerotiorum. BioControl 2010, 55, 811–819. [Google Scholar] [CrossRef]
- Zucchi, T.D.; Almeida, L.G.; Moraes, L.A.B.; Cônsoli, F.L. Albocycline, the Main Bioactive Compound from Propionicimonas sp. ENT-18 against Sclerotinia Sclerotiorum. Ind. Crops Prod. 2014, 52, 264–268. [Google Scholar] [CrossRef]
- Gu, C.Z.; Yuan, S.H.; Jing, L.; Qiao, Y.J.; Song, Y.Y.; Abdalla Elzaki, M.E.; Yang, C.R.; Zhang, Y.J.; Zeng, R. Sen Albocycline-Type Macrolides with Antibacterial Activities from Streptomyces sp. 4205. Chem. Biodivers. 2019, 16, e1800344. [Google Scholar] [CrossRef]
- Ohike, T.; Matsukawa, T.; Okanami, M.; Kajiyama, S.; Ano, T. Biological Control Potential of Streptomyces sp. AR10 Producing Albocycline Isolated from Soil around Ant Nest. J. Agric. Sci. 2018, 10, 54. [Google Scholar] [CrossRef]
- Koyama, N.; Yotsumoto, M.; Onaka, H.; Tomoda, H. New Structural Scaffold 14-Membered Macrocyclic Lactone Ring for Selective Inhibitors of Cell Wall Peptidoglycan Biosynthesis in Staphylococcus aureus. J. Antibiot. 2013, 66, 303–304. [Google Scholar] [CrossRef]
- Nagahama, N.; Takamori, I.; Kotera, K.; Suzuki, M. Studies on an Antibiotic, Albocycline. Chem. Pharm. Bull. 1971, 19, 619–654. [Google Scholar] [CrossRef]
- Thomas, R.C.; Chidester, C.G. Albocycline: Structure Determination by X-ray Crystallography. J. Antibiot. 1982, 35, 1658–1664. [Google Scholar] [CrossRef]
- Stukenbrock, E.; Gurr, S. Address the Growing Urgency of Fungal Disease in Crops. Nature 2023, 617, 31–34. [Google Scholar] [CrossRef]
- Bebber, D.P.; Holmes, T.; Gurr, S.J. The Global Spread of Crop Pests and Pathogens. Glob. Ecol. Biogeogr. 2014, 23, 1398–1407. [Google Scholar] [CrossRef]
- Almeida, F.; Rodrigues, M.L.; Coelho, C. The Still Underestimated Problem of Fungal Diseases Worldwide. Front. Microbiol. 2019, 10, 214. [Google Scholar] [CrossRef]
- O’Sullivan, C.A.; Belt, K.; Thatcher, L.F. Tackling Control of a Cosmopolitan Phytopathogen: Sclerotinia. Front. Plant Sci. 2021, 12, 707509. [Google Scholar] [CrossRef] [PubMed]
- Bérdy, J. Bioactive Microbial Metabolites. J. Antibiot. 2005, 58, 1–26. [Google Scholar] [CrossRef] [PubMed]
- Köhl, J.; Kolnaar, R.; Ravensberg, W.J. Mode of Action of Microbial Biological Control Agents against Plant Diseases: Relevance beyond Efficacy. Front. Plant Sci. 2019, 10, 845. [Google Scholar] [CrossRef] [PubMed]
- Pacios-Michelena, S.; Aguilar González, C.N.; Alvarez-Perez, O.B.; Rodriguez-Herrera, R.; Chávez-González, M.; Arredondo Valdés, R.; Ascacio Valdés, J.A.; Govea Salas, M.; Ilyina, A. Application of Streptomyces Antimicrobial Compounds for the Control of Phytopathogens. Front. Sustain. Food Syst. 2021, 5, 696518. [Google Scholar] [CrossRef]
- Nagahama, N.; Suzuki, M.; Awataguchi, S.; Okuda, T. Studies on a New Antibiotic, Albocycline. I. Isolation, Purification and Properties. J. Antibiot. 1967, 20, 261–266. [Google Scholar]
- Harada, K.I.; Nishida, F.; Takagi, H.; Suzuki, M.; Iwashita, T. Studies on an Antibiotic, Albocycline VII. Minor Components of Albocycline. J. Antibiot. 1984, 37, 1187–1197. [Google Scholar] [CrossRef]
- Furumai, T.; Nagahama, N.; Okuda, T. Studies on a New Antibiotic, Albocycline. II. Taxonomic Studies on Albocycline-Producing Strains. J. Antibiot. 1968, 21, 85–90. [Google Scholar] [CrossRef]
- Miyairi, N.; Takashima, M.; Shimizu, K.; Sakai, H. Studies on New Antibiotics, Cineromycins A and B. J. Antibiot. 1966, 19, 56–62. [Google Scholar]
- Daher, S.S.; Franklin, K.P.; Scherzi, T.; Dunman, P.M.; Andrade, R.B. Synthesis and Biological Evaluation of Semi-Synthetic Albocycline Analogs. Bioorg. Med. Chem. Lett. 2020, 30, 127509. [Google Scholar] [CrossRef]
- Slechta, L.; Cialdella, J.; Hoeksema, H. Biomodification of Albocycline by Streptomyces venezuelae. J. Antibiot. 1978, 31, 319–323. [Google Scholar] [CrossRef]
- Küster, E.; Williams, S. Selection of Media for Isolation of Streptomycetes. Nature 1964, 202, 928–929. [Google Scholar] [CrossRef] [PubMed]
- Kieser, T.; Bibb, M.; Buttner, M.; Chater, K.; Hopwood, D. Practical Streptomyces Genetics; John Innes Foundation: Norwich, UK, 2000; ISBN 0708406238. [Google Scholar]
- Hopwood, D.A.; Bibb, M.J.; Chater, K.F.; Bruton, C.J.; Kieser, H.M.; Lydiate, D.; Smith, C.P.; Ward, J.M.; Schrempf, H. Genetic Manipulation of Streptomyces: A Laboratory Manual; The John Innes Institute: Norwich, UK, 1985. [Google Scholar]
- Lane, D. 16S/23S RRNA Sequencing. In Nucleic Acid Techniques in Bacterial Systematics; Stackebrandt, E., Goodfellow, M., Eds.; John Wiley and Sons: New York, NY, USA, 1991; pp. 115–175. [Google Scholar]
- Kim, O.S.; Cho, Y.J.; Lee, K.; Yoon, S.H.; Kim, M.; Na, H.; Park, S.C.; Jeon, Y.S.; Lee, J.H.; Yi, H.; et al. Introducing EzTaxon-e: A Prokaryotic 16S RRNA Gene Sequence Database with Phylotypes That Represent Uncultured Species. Int. J. Syst. Evol. Microbiol. 2012, 62, 716–721. [Google Scholar] [CrossRef] [PubMed]
- Kimura, M. A Simple Method for Estimating Evolutionary Rates of Base Substitutions through Comparative Studies of Nucleotide Sequences. J. Mol. Evol. 1980, 16, 111–120. [Google Scholar] [CrossRef] [PubMed]
- Guo, Y.P.; Zheng, W.; Rong, X.Y.; Huang, Y. A Multilocus Phylogeny of the Streptomyces griseus 16S RRNA Gene Clade: Use of Multilocus Sequence Analysis for Streptomycete Systematics. Int. J. Syst. Evol. Microbiol. 2008, 58, 149–159. [Google Scholar] [CrossRef]
- Rong, X.; Guo, Y.; Huang, Y. Proposal to Reclassify the Streptomyces albidoflavus Clade on the Basis of Multilocus Sequence Analysis and DNA-DNA Hybridization, and Taxonomic Elucidation of Streptomyces griseus subsp. solvifaciens. Syst. Appl. Microbiol. 2009, 32, 314–322. [Google Scholar] [CrossRef]
- Álvarez-Pérez, J.M.; González-García, S.; Cobos, R.; Olego, M.Á.; Ibañez, A.; Díez-Galán, A.; Garzón-Jimeno, E.; Coque, J.J.R. Use of Endophytic and Rhizosphere Actinobacteria from Grapevine Plants to Reduce Nursery Fungal Graft Infections That Lead to Young Grapevine Decline. Appl. Environ. Microbiol. 2017, 83, e01564-17. [Google Scholar] [CrossRef]
- Collado-Romero, M.; Mercado-Blanco, J.; Olivares-García, C.; Valverde-Corredor, A.; Jiménez-Díaz, R.M. Molecular Variability within and among Verticillium dahliae Vegetative Compatibility Groups Determined by Fluorescent Amplified Fragment Length Polymorphism and Polymerase Chain Reaction Markers. Phytopathology 2006, 96, 485–495. [Google Scholar] [CrossRef]
- Senthilkumar, M.; Amaresan, N.; Sankaranarayanan, A. Antagonistic Activity of Volatile Compound of bacteria against Phytopathogens: Dual Plate Assay. In Plant-Microbe Interactions. Springer Protocols Handbooks; Humana: New York, NY, USA, 2021; pp. 171–173. ISBN 978-1-0716-1079-4. [Google Scholar]
- Martin, J.F.; McDaniel, L.E. Biosynthesis of Candicidin by Phosphate-Limited Resting Cells of Streptomyces griseus. Eur. J. Appl. Microbiol. 1976, 3, 135–144. [Google Scholar] [CrossRef]
- Schrey, S.D.; Erkenbrack, E.; Früh, E.; Fengler, S.; Hommel, K.; Horlacher, N.; Schulz, D.; Ecke, M.; Kulik, A.; Fiedler, H.P.; et al. Production of Fungal and Bacterial Growth Modulating Secondary Metabolites Is Widespread among Mycorrhiza-Associated Streptomycetes. BMC Microbiol. 2012, 12, 164. [Google Scholar] [CrossRef]
- Tan, K.H. Soil Sampling, Preparation, and Analysis, 2nd ed.; CRC Press: New York, NY, USA, 2005; ISBN 9780429178993. [Google Scholar]
- Batjes, N.H. Total Carbon and Nitrogen in the Soils of the World. Eur. J. Soil Sci. 1996, 47, 151–163. [Google Scholar] [CrossRef]
- Ostrowska, A.; Gawlinski, S.; Szczubialka, Z. Methods for Analysis and Evaluation of Soil and Plant Properties. IOŚ Warszawa 1991, 334, 158–167. [Google Scholar]
- Houba, V.J.G.; Temminghoff, E.J.M.; Gaikhorst, G.A.; van Vark, W. Soil Analysis Procedures Using 0.01 M Calcium Chloride as Extraction Reagent. Commun. Soil Sci. Plant Anal. 2000, 31, 1299–1396. [Google Scholar] [CrossRef]
- Das, R.; Romi, W.; Das, R.; Sharma, H.K.; Thakur, D. Antimicrobial Potentiality of Actinobacteria Isolated from Two Microbiologically Unexplored Forest Ecosystems of Northeast India. BMC Microbiol. 2018, 18, 71. [Google Scholar] [CrossRef] [PubMed]
- Awla, H.K.; Rashid, T.S. HPLC Fractionation: A Comparative Analysis of Anti-Fungal Compounds from Different Streptomyces Isolates Inhibiting Colletotrichum acutatum. Biocatal Agric. Biotechnol. 2020, 27, 101688. [Google Scholar] [CrossRef]
- López-Moral, A.; Agustí-Brisach, C.; Leiva-Egea, F.M.; Trapero, A. Influence of Cultivar and Biocontrol Treatments on the Effect of Olive Stem Extracts on the Viability of Verticillium dahliae Conidia. Plants 2022, 11, 554. [Google Scholar] [CrossRef]
- Bauer, A.W.; Kirby, W.M.M.; Sherrys, J.C.; Turck, M. Antibiotic Susceptibility Testing by a Standardized Single Disk Method. Am. J. Clin. Pathol. 1966, 45, 493–496. [Google Scholar] [CrossRef]
- Tenover, F.C. Antimicrobial Susceptibility Testing. In Encyclopedia of Microbiology; Academic Press: Cambridge, MA, USA, 2019; pp. 166–175. ISBN 9780128117378. [Google Scholar]

| MLSA (Kimura 2-Parameter) Distance * | ||||||
|---|---|---|---|---|---|---|
| Strain | OR6 | OR14 | OR58 | OR67 | OR92 | OR96 |
| Streptomyces sp. OR6 | ||||||
| Streptomyces sp. OR14 | 0.002 | |||||
| Streptomyces sp. OR58 | 0.130 | 0.130 | ||||
| Streptomyces sp. OR67 | 0.113 | 0.112 | 0.095 | |||
| Streptomyces sp. OR92 | 0.004 | 0.002 | 0.132 | 0.114 | ||
| Streptomyces sp. OR96 | 0.111 | 0.111 | 0.114 | 0.099 | 0.112 | |
| Streptomyces chattanoogensis NRRL ISP5002 | 0.044 | 0.043 | 0.128 | 0.127 | 0.045 | 0.112 |
| Streptomyces longispororuber NRRL B3736 | 0.125 | 0.125 | 0.014 | 0.097 | 0.127 | 0.109 |
| Streptomyces anulatus NRRL B2000 | 0.127 | 0.127 | 0.013 | 0.099 | 0.129 | 0.110 |
| Streptomyces wuyuanensis CGMCC 4,7042 | 0.115 | 0.113 | 0.111 | 0.047 | 0.115 | 0.102 |
| Streptomyces hygroscopicus subsp. ossamyceticus NRRL B3822 | 0.114 | 0.114 | 0.118 | 0.103 | 0.116 | 0.018 |
| Receiver Strain | Tester Strain | |||||||
|---|---|---|---|---|---|---|---|---|
| OR6 | OR58 | OR67 | OR96 | |||||
| Ii (%) | SD | Ii (%) | SD | Ii (%) | SD | Ii (%) | SD | |
| OR6 | 0.44 | 0.88 | 6.00 | 1.73 | 0.00 | 0.00 | ||
| OR58 | 10.44 | 0.88 | 3.33 | 1.73 | 0.00 | 0.00 | ||
| OR67 | 27.33 | 2.83 | 8.00 | 1.41 | 0.00 | 0.00 | ||
| OR96 | 20.00 | 2.24 | 6.44 | 1.67 | 2.44 | 1.67 | ||
| Strain | Genbank Accession Numbers | |||||
|---|---|---|---|---|---|---|
| 16S rRNA | atpD | gyrB | recA | rpoB | trpB | |
| OR6 | OR506195 | OR527395 | OR527401 | OR527407 | OR527413 | OR527419 |
| OR14 | OR506196 | OR527396 | OR527402 | OR527408 | OR527414 | OR527420 |
| OR58 | OR506197 | OR527397 | OR527403 | OR527409 | OR527415 | OR527421 |
| OR67 | OR506198 | OR527398 | OR527404 | OR527410 | OR527416 | OR527422 |
| OR92 | OR506199 | OR527399 | OR527405 | OR527411 | OR527417 | OR527423 |
| OR96 | OR506200 | OR527400 | OR527406 | OR527412 | OR527418 | OR527424 |
Disclaimer/Publisher’s Note: The statements, opinions and data contained in all publications are solely those of the individual author(s) and contributor(s) and not of MDPI and/or the editor(s). MDPI and/or the editor(s) disclaim responsibility for any injury to people or property resulting from any ideas, methods, instructions or products referred to in the content. |
© 2023 by the authors. Licensee MDPI, Basel, Switzerland. This article is an open access article distributed under the terms and conditions of the Creative Commons Attribution (CC BY) license (https://creativecommons.org/licenses/by/4.0/).
Share and Cite
Calvo-Peña, C.; Cobos, R.; Sánchez-López, J.M.; Ibañez, A.; Coque, J.J.R. Albocycline Is the Main Bioactive Antifungal Compound Produced by Streptomyces sp. OR6 against Verticillium dahliae. Plants 2023, 12, 3612. https://doi.org/10.3390/plants12203612
Calvo-Peña C, Cobos R, Sánchez-López JM, Ibañez A, Coque JJR. Albocycline Is the Main Bioactive Antifungal Compound Produced by Streptomyces sp. OR6 against Verticillium dahliae. Plants. 2023; 12(20):3612. https://doi.org/10.3390/plants12203612
Chicago/Turabian StyleCalvo-Peña, Carla, Rebeca Cobos, José María Sánchez-López, Ana Ibañez, and Juan José R. Coque. 2023. "Albocycline Is the Main Bioactive Antifungal Compound Produced by Streptomyces sp. OR6 against Verticillium dahliae" Plants 12, no. 20: 3612. https://doi.org/10.3390/plants12203612
APA StyleCalvo-Peña, C., Cobos, R., Sánchez-López, J. M., Ibañez, A., & Coque, J. J. R. (2023). Albocycline Is the Main Bioactive Antifungal Compound Produced by Streptomyces sp. OR6 against Verticillium dahliae. Plants, 12(20), 3612. https://doi.org/10.3390/plants12203612

